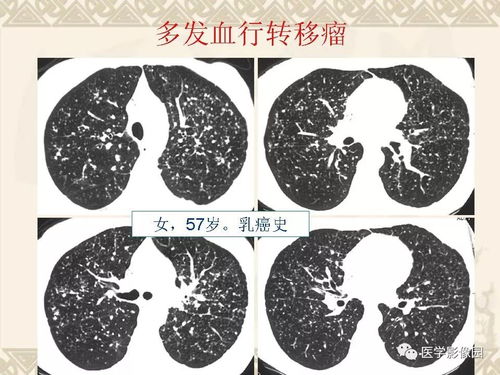
梅毒治疗的方法都有哪些呀 梅毒治疗的方法都有哪些呀

梅毒治疗的方法都有哪些呀
梅毒的治疗堪称多样且富有,背后蕴藏着中医丰富的理论和实践智慧。在中医的视野中,梅毒的成因被归结为淫毒内侵,耗伤气血,并涉及多个脏腑功能失调。在治疗上,中医秉持着独特的理念,强调驱邪解毒与调养身心并重,以期达到标本兼治的效果。
对于肝经湿热证的患者,治疗方法为清热利湿,解毒驱梅。以龙胆泻肝汤为主方,这剂药方汇集了龙胆草、黄芩、栀子等药材,它们协同作用,共同泻火解毒祛湿。辅以木通、车前子等利湿之品,形成一道防线,有效清热利湿、解毒驱梅。
对于肺脾湿热证,则需要清泄肺脾,同样辅以解毒驱梅。杨梅一剂散是此证的主方,它包含了白芷、蝉蜕等药物,能够宣散在表之湿热以驱梅。而金银花、连翘等则清泄在里之湿热以解毒。
对于痰湿流聚证,重点在于化痰散结,祛湿驱梅。海藻玉壶汤是治疗的良方,它包含的贝母、半夏等药物能够化痰软坚散结。再配合连翘、甘草等解毒祛湿之品,共同为身体清理梅毒的困扰。
对于热毒蕴结证,治疗的核心在于清热泻火,同样辅以解毒驱梅。黄连解毒汤合五味消毒饮为主方,其中的黄连、黄芩等药物能够清泻三焦实火。蒲公英、紫花地丁等则具有清热解毒的卓越效果。
中医治疗梅毒的方法虽与西医有所不同,但其核心治疗原则是一致的,都是根据梅毒的分期进行治疗。相较于西医,中医治疗的效果更温和且持久。值得一提的是,早期治疗是梅毒治疗的关键。在日常生活中,预防梅毒同样重要。保持健康的生活习惯,洁身自好,避免不洁性行为,是预防梅毒的根本。增强自身免疫力,通过合理膳食和适度运动,也是预防梅毒的重要措施。
梅毒的治疗需要综合考虑患者的具体情况,选择合适的治疗方法。中医治疗梅毒具有独特的优势,结合患者的实际情况进行个体化的治疗是关键。希望大家能够更好地了解梅毒的治疗方法,为防治梅毒贡献一份力量。同时也提醒大家,对待梅毒要有科学的态度,既要重视治疗也要重视预防。